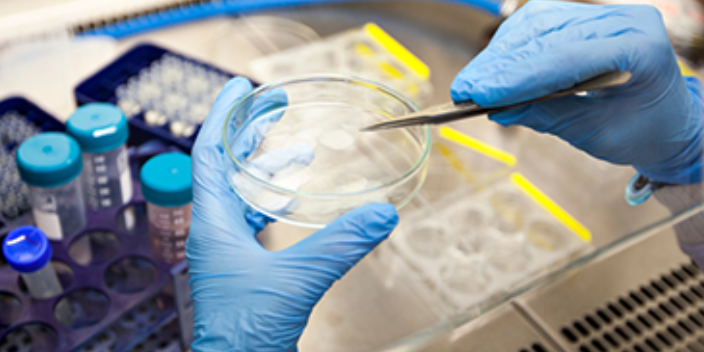
云南動(dòng)物造模實(shí)驗(yàn)外包價(jià)位 來電咨詢 南京英瀚斯生物科技供應(yīng)

2025-10-28 00:12:56
HE染色全名為蘇木精和伊紅染色方法,是**基本的病理學(xué)染色技術(shù)。由于組織或細(xì)胞的不同成分對(duì)蘇木精的親和力不同及染色性質(zhì)不一樣。經(jīng)蘇木精染色后,細(xì)胞核及鈣鹽粘液等呈藍(lán)色,可用鹽酸酒精分化和弱堿性溶液顯藍(lán),如處理適宜,可使細(xì)胞核著清楚的深藍(lán)色,胞漿等其它成分脫色。再利用胞漿染料伊紅染胞漿,使胞漿的各種不同成分又呈現(xiàn)出深淺不同的粉紅色。故各種組織或細(xì)胞成分與病變的一般形態(tài)結(jié)構(gòu)特點(diǎn)均可顯示出來。質(zhì)量好的HE具備條件1.細(xì)胞核與細(xì)胞漿藍(lán)紅相映,鮮艷亮麗;2.胞核鮮明、核膜、核染色質(zhì)顆粒均清晰可見;3.組織或一般結(jié)構(gòu)特點(diǎn)及假物質(zhì)成分均能顯示出來??蒲谐鋵?shí)驗(yàn)操作之HE染色。湖南專業(yè)的HE染色多少錢

HE染色:在組織病理學(xué)中,蘇木素-伊紅染色是一種日常使用比較普遍的常規(guī)染色方法。常規(guī)蘇木素染色的對(duì)比染色是用伊紅,也有采用焰紅,因?yàn)檠婕t比伊紅色澤更鮮明,還有采用橘黃G,比布里希猩紅,波爾多紅等作為對(duì)比染色。伊紅是比較常用的胞質(zhì)染料,本身溶于醇而不溶于水,為磚紅色粉末狀或醬紅色結(jié)晶。配方:伊紅Y(水溶)0.5-1g,蒸餾水99ml。如果取用伊紅Y(醇溶性)應(yīng)當(dāng)溶于99ml 75%或95%的乙醇中。如果在伊紅液中加入0.5ml冰醋酸,可以加速其染色過程,使得胞質(zhì)的色澤更加艷麗。結(jié)果是細(xì)胞核呈藍(lán)色,胞質(zhì)、肌肉、結(jié)締組織、紅細(xì)胞和嗜伊紅顆粒呈不同程度的紅色。鈣鹽和各種微生物也可染成藍(lán)色或紫藍(lán)色。貴州質(zhì)量好的HE染色哪家好HE染色規(guī)范化流程及注意事項(xiàng)?

HE染色常見問題:成片的染色模糊不清,灰染答:(1)組織未及時(shí)固定,部分自溶;或固定不佳,深部組織未處理到。這種只能重新固定了。(2)盡管乙醇也是一種固定液,但盡量少用或不用,因?yàn)槠鋾?huì)導(dǎo)致組織發(fā)硬變脆,染色效果不好。(3)包埋時(shí)蠟的溫度過高,或切片后烤片時(shí)間和溫度過久過高都不好,可能會(huì)導(dǎo)致無法染色。(4)脫蠟不徹底;染料有問題;分化過度導(dǎo)致的顏色變淡,鏡下組織界限不清;染完后的脫水和透明不佳,水霧殘留在組織上。(5)通風(fēng)窗中(防止空氣中的水霧),戴口罩操作封片(減少哈氣帶來的水霧)。
HE染色分化作用:染色后,用某些特定的溶液將組織過多結(jié)合的染色劑脫去,這個(gè)過程稱為分化作用,所用的溶液稱為分化液。在HE染色中用0.5%鹽酸乙醇作為分化液,因酸能破壞蘇木精的醌型結(jié)構(gòu),使組織與色素分離而褪色。經(jīng)蘇木精染色后,必須用0.5%鹽酸乙醇分化,使細(xì)胞核過多結(jié)合的蘇木精染料和細(xì)胞漿吸附的蘇木精染料脫去,在進(jìn)行伊紅染色,才能保證細(xì)胞核與細(xì)胞漿染色的分明。因此,在HE染色中分化是極為關(guān)鍵的一步。返藍(lán)作用:分化之后,蘇木精在酸性條件下處于紅色離子狀態(tài),呈紅色,在堿性條件下處于藍(lán)色離子狀態(tài),呈藍(lán)色。組織切片經(jīng)0.5%鹽酸乙醇分化后呈紅色或粉紅色,故分化之后,立即用水出去組織切片上的酸而終止分化,再用弱堿性水(0.2%氨水)使蘇木精染上的細(xì)胞核呈現(xiàn)藍(lán)色,這個(gè)過程稱為返藍(lán)作用或藍(lán)化作用。另外用自來水浸洗也可使細(xì)胞核返藍(lán),但所需時(shí)間較長。HE染色,優(yōu)先南京英瀚斯生物。

HE染色主要是為通細(xì)胞及胞核形態(tài)、大小來區(qū)別各種細(xì)胞的,并不是直接通過顏色來區(qū)分的,HE染色細(xì)胞壞死的三種改變:(1)細(xì)胞核的改變:這是細(xì)胞壞死的主要形態(tài)標(biāo)志,表現(xiàn)為核濃縮,核碎裂,核溶解。(2)細(xì)胞質(zhì)的改變:由于胞質(zhì)發(fā)生凝固或溶解,HE染色呈深紅色顆粒狀,如肝細(xì)胞壞死出現(xiàn)的嗜酸性小體醫(yī)學(xué)|教育網(wǎng)搜集整理。(3)間質(zhì)的改變:由于各種溶解酶的作用,基質(zhì)崩解、膠原纖維腫脹、斷裂或液化,與壞死的細(xì)胞融合成一片,呈紅染的顆粒狀無結(jié)構(gòu)物質(zhì)。南京英瀚斯生物HE染色,南京英瀚斯,專業(yè)的實(shí)驗(yàn)外包公司。湖南專業(yè)的HE染色多少錢
比較常見的病理染色HE染色?湖南專業(yè)的HE染色多少錢
HE染色標(biāo)本一般是針對(duì)石蠟標(biāo)本,脂滴和石蠟都是的有機(jī)物, 都具有非極,脂滴應(yīng)該可以溶解石蠟的。 HE染色就是用蘇木精和伊紅對(duì)細(xì)胞內(nèi)的核糖體和細(xì)胞質(zhì)染色的方法。 H:Hematoxylin,蘇木精 E:Eosin,伊紅 蘇木精(Hematoxylin,H)是一種堿染料,可將細(xì)胞核和細(xì)胞內(nèi)核糖體染成藍(lán)紫色,被堿染料染色的結(jié)構(gòu)具有嗜堿。 伊紅(,E)是一種酸染料,能將細(xì)胞質(zhì)染成紅色或淡紅色,被酸染料染色的結(jié)構(gòu)具有嗜酸。染色前,須用二甲苯脫去切片中的石蠟,再經(jīng)由高濃度到低濃度酒精,***入蒸餾水,就可染色。南京英瀚斯生物湖南專業(yè)的HE染色多少錢